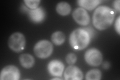
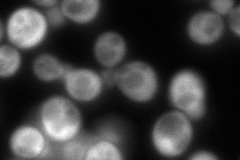
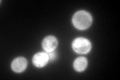

View description
Cystathionine beta-synthase, catalyzes synthesis of cystathionine from serine and homocysteine, the first committed step in cysteine biosynthesis; responsible for hydrogen sulfide generation; mutations in human ortholog cause homocystinuria
Localization:
Intensity:
Fold change:
Significance:
-
C’ GFP library in SD
punctate, cytosol591.29 -
N' NOP1pr-GFP in SD

cytosol233.636 -
N' TEF2pr-mCherry in SD

cytosol251.548 -
N' NATIVEpr-GFP in SD
cytosol284.214 -
N' TEF2pr-VC and Cyto-VN in SD

#N/A0 -
C’ GFP library in SD+DTT

punctate, cytosol822.31.39No -
C’ GFP library in SD+H2O2

punctate, cytosol668.141.12No -
C’ GFP library in Starvation Media
cytosolN/AN/AYes -
C’ GFP library on the background of Pup2-DaMP

punctate, cytosol -
C’ GFP library on the background of CCT mutant

punctate, cytosol827.5071.39946Yes
